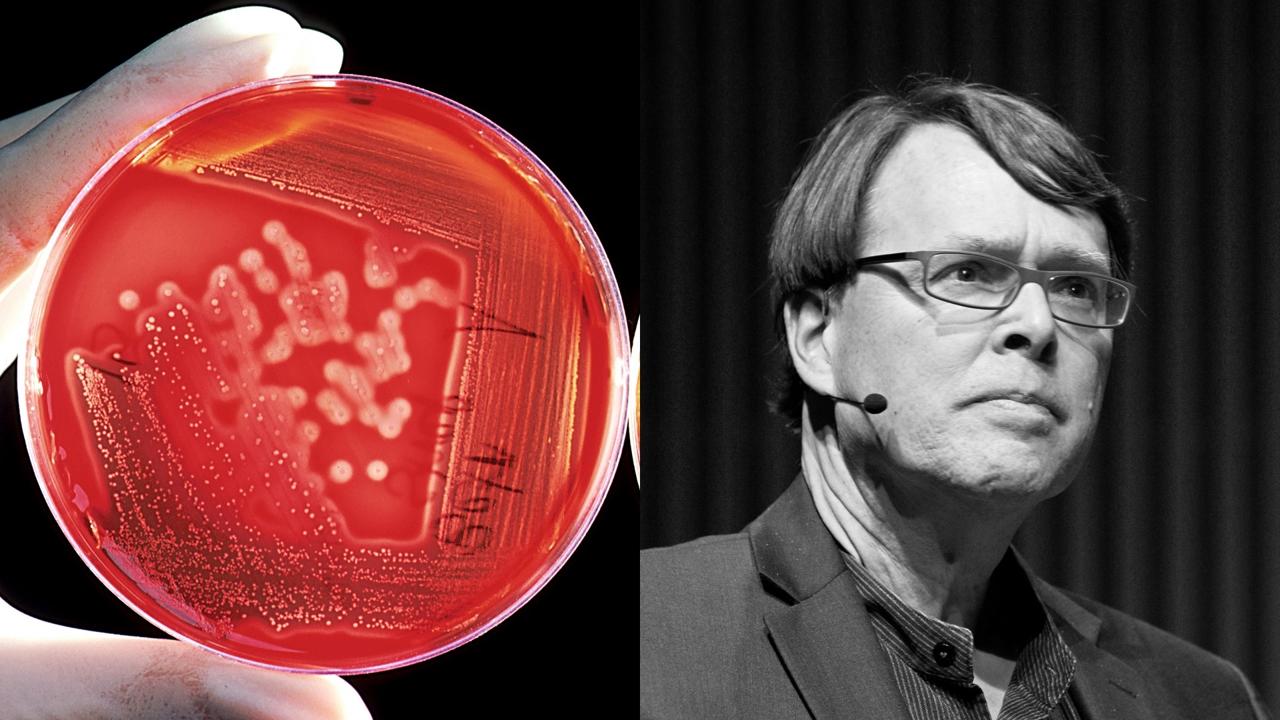

Charles C. Mann
The Wizard and the Prophet
Recorded live on Jan 22, 02018
at SFJAZZ Center
Two ways to save humanity
Mann titled his talk “The Edge of the Petri Dish.” He explained, “If you drop a couple protozoa in a Petri dish filled with nutrient goo, they will multiply until they run out of resources or drown in their own wastes.” Humans in the world Petri dish appear to be similarly doomed, judging by our exponential increases in population, energy use, water use, income, and greenhouse gases.
How to save humanity? Opposing grand approaches emerged from two remarkable scientists in the mid-20th century who fought each other their entire lives. Their solutions were so persuasive that their impassioned argument continues 70 years later to dominate how we think about dealing with the still-exacerbating exponential impacts.
Norman Borlaug, the one Mann calls “the Wizard,” was a farm kid trained as a forester. In 1944 he found himself in impoverished Mexico with an impossible task—solve the ancient fungal killer of wheat, rust. First he invented high-volume crossbreeding, then shuttle breeding (between winter wheat and spring wheat), and then semi-dwarf wheat. The resulting package of hybrid seeds, synthetic fertilizer, and irrigation became the Green Revolution that ended most of hunger throughout the world for the first time in history.
There were costs. The diversity of crops went down. Excess fertilizer became a pollutant. Agriculture industrialized at increasing scale, and displaced smallhold farmers fled to urban slums.
William Vogt, who Mann calls “the Prophet,” was a poor city kid who followed his interest in birds to become an isolated researcher on the revolting guano islands of Peru. He discovered that periodic massive bird die-offs on the islands were caused by the El Niño cycle pushing the Humboldt Current with its huge load of anchovetas away from the coast and starving the birds. The birds were, Vogt declared, subject to an inescapable “carrying capacity.“ That became the foundational idea of the environmental movement, later expressed in terms such as “limits to growth,” “ecological overshoot,” and “planetary boundaries.” Vogt spelled out the worldview in his powerful 1948 book, The Road to Survival.
The Prophets-versus-Wizards debate keeps on raging—artisanal organic farming versus factory-like mega-farms; distributed solar energy versus centralized fossil fuel refineries and nuclear power plants; dealing with climate change by planting a zillion trees versus geoengineering with aerosols in the stratosphere. The question continues: How do we best manage our world Petri dish? Restraint? Or innovation?
Can humanity change its behavior at planet scale? Mann ended by pointing out that in 1800 slavery was universal in the world and had been throughout history. Then it ended. How? Prophets say that morally committed abolitionists did it. Wizards say that clever labor-saving machinery did it.
Maybe it was the combination.
watch
bio
Science journalist Charles C. Mann is author of 1491: New Revelations of the Americas Before Columbus (02006), 1493: Uncovering the New World Columbus Created (02012) and The Wizard and the Prophet: Two Remarkable Scientists and Their Dueling Visions to Shape Tomorrow's World (02018).
Join our newsletter for the latest in long-term thinking
Subscribe